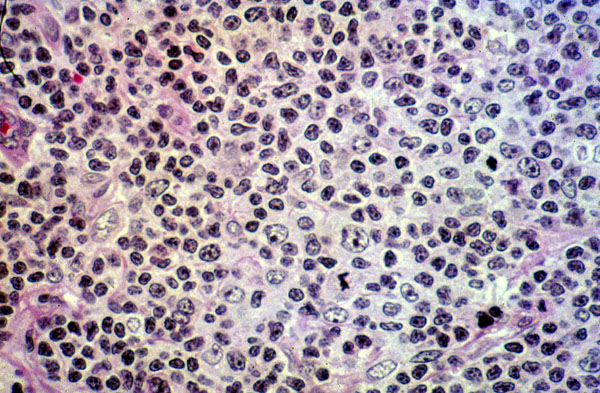

Non-Hodgkin lymphoma, diffuse mixed cell type, histology
Click picture to enlarge. Close window to return
This lymph node is involved by a lymphoma showing a diffuse growth pattern, and mixed small and large cell types. How would you classify this lymphoma in the Working Formulation?